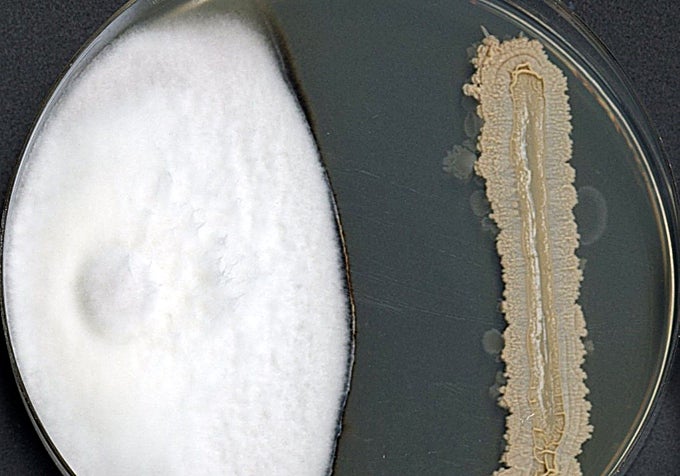
Proyecto BioBIVE: en la imagen, a la izquierda un hongo patógeno de plantas (fresa, zanahoria o tomate) y a la derecha un microorganismo capaz de retrasar el crecimiento de los patógenos. Las sustancias generadas o los propios microorganismos son los biopesticidas

Elaborados a partir de plantas, microorganismos o minerales, los biopesticidas son la evolución natural del sector agrícola. Innovación y sostenibilidad sobre el terreno en la transición de lo químico a lo biológico, con España en vanguardia, consolidada como ‘hub’ tecnológico en este ámbito. Todo un despliegue de maravillas como las propias del ARN de Interferencia y el ‘apagado de genes’: se diseñan moléculas que, al ser ingeridas por una plaga específica, ‘apagan’ un gen vital para su supervivencia, sin influir en ninguna otra especie del ecosistema. Es, literalmente, programar la naturaleza para defenderse.Un ejemplo de esta nueva era se demuestra, día a día, en los laboratorios de la Universidad de León. Carlos Barreiro, profesor titular del Departamento de Biología Molecular de la Facultad de Veterinaria (y miembro de SEBiot-Sociedad Española de Biotecnología), establece una situación de partida: «El sector agrícola se enfrenta constantemente a retos que necesita superar para poder garantizar su continuidad, con lo que ello representa respecto al nivel de conservación de variedades vegetales autóctonas, el mantenimiento de la población en el entorno rural y la preservación de una actividad de alto impacto en el PIB español y europeo». Desafíos legales (control del uso de fitosanitarios por la UE), productivos (aumento de la población mundial), económicos (competencia con otros productores con diferentes regulaciones) y climáticos (que favorecen la emergencia de nuevas plagas o la resistencia de las existentes).Barreiro coordina el proyecto BioBIVE, en línea con el concepto de transición de las prácticas agrícolas convencionales a las regenerativas propuesto por el Comité Económico y Social Europeo en 2025. «El control de plagas (destaca Barreiro) presenta varios puntos de actuación, como el combate contra los hongos (mohos) que afectan a cultivos (tres de los productos en los que España ocupa el ‘top 3’ de productores europeos: fresa, zanahoria y tomate, centran las actividades de BioBIVE). El desafío es lograr que el efecto no sea puntual, sino que se mantenga durante el tiempo necesario para proteger los cultivos». El proyecto propone tres formas de liberación controlada de los biopesticidas «el plástico biodegradable de mulch (mantillo), el biochar (biocarbón) y el novedoso mulch pulverizable, a partir de materiales biológicos (quitosano, pectina)». Como bonus, el proyecto abre una ventana de oportunidad para la industria del plástico en Europa «al ampliar su porfolio de productos hacia horizontes más ecosostenibles, lo que facilitará el mantenimiento de empresas».Trabajos de referenciaOtro ejemplo de referencia es la Universidad de Almería (Almería ya cuenta con más de 5.500 hectáreas de cultivo ecológico certificado), con proyectos como Greenfarm y Sabana (microalgas que llegan a ayudar a la planta a crecer y refuerzan sus defensas naturales contra patógenos), Adopt IPM (una alianza UE-China para luchar contra las plagas con una significativa reducción de químicos), el centro de investigación Ciambital, etc. Todo suma para que se pueda materializar la estrategia ‘De la Granja a la Mesa’ (‘Farm to Fork’), una iniciativa clave del Pacto Verde Europeo, lanzada en 2020, que aspira a reducir el uso de plaguicidas químicos en un 50% para finales de esta década. Un desempeño en el que los biopesticidas cuentan con tres vectores de desarrollo: la opción microbiana (microorganismos vivos como bacterias, hongos, virus o protozoos), la bioquímica (sustancias naturales que controlan plagas mediante mecanismos no tóxicos, como feromonas que confunden a los machos y evitan la reproducción) y los ‘Protectores incorporados’ (PIP), sustancias producidas por las plantas modificadas genéticamente con material de biopesticidas (con restricciones, eso sí, de la UE).La innovación abierta es clave para llevar la soluciones de laboratorio a los cultivosOtros de los laboratorios punteros en España son los del CSIC, cuyo Grupo de Bioplaguicidas desarrolla investigaciones en las que la ciencia aplicada convive con procesos industriales escalables. «El grupo no es solo un equipo de investigación, es una plataforma estratégica diseñada para acelerar el desarrollo de soluciones biotecnológicas antes de su uso en campo. Nuestro valor diferencial es integrar microbiología, genética, química verde, y escalado industrial en un mismo entorno», apuntan desde CSIC. Un equipo multidisciplinar trabaja en laboratorios especializados en microbiología, biología de insectos plaga y fitoparásitos, análisis metabolómico, formulación avanzada, compatibilidad agronómica y evaluación biológica, con invernaderos experimentales y campos de ensayo. Sus trabajos abarcan desde la prospección de plantas y el aislamiento de microorganismos, que produzcan metabolitos potencialmente activos para el control de plagas y enfermedades de los cultivos, «hasta el diseño de formulados de productos naturales que potencian la resiliencia de las plantas frente al estrés biótico». Una gama de posibilidades en las que exprimen su experiencia en el estudio del microbioma asociado a los suelos y plantas cultivadas y su función en los agroecosistemas, así como de la epidemiología de ciertos organismos fitopatógenos como hongos y nematodos.Desde la empresa Biorizon Biotech destacan cómo «los biopesticidas han pasado de ser alternativa emergente a convertirse en pieza clave en la transformación del modelo agrícola». Su aportación pasa por entenderlos no como productos aislados, sino como parte de un sistema tecnológico más amplio orientado a mejorar la resiliencia del cultivo, con desarrollos como la tecnología Trietech: una plataforma biotecnológica cuyo eje central es un sistema propio que integra distintas fuentes biológicas (microalgas, bacterias y extractos vegetales) para desarrollar soluciones agrícolas de alto valor añadido.Los laboratorios de CSIC son referentes en este ámbito; sobre estas líneas, un desarrollo de la Universidad de LeónProyecto BioBIVE: en la imagen, a la izquierda un hongo patógeno de plantas (fresa, zanahoria o tomate) y a la derecha un microorganismo capaz de retrasar el crecimiento de los patógenos. Las sustancias generadas o los propios microorganismos son los biopesticidas«La biotecnología y las microalgas (señala su director general, Sergio Aguilar) nos ofrecen innumerables soluciones futuras a través de la síntesis natural de los metabolitos con gran valor agronómico. Se integran en Trietech, que no se basa en un único ingrediente activo, sino en la combinación sinérgica de compuestos bioactivos naturales obtenidos mediante procesos biotecnológicos avanzados». Un círculo virtuoso de naturaleza y tecnología que consigue activar las defensas naturales del cultivo, mejorar el estado fisiológico de la planta, su refuerzo estructural, la interferencia en el desarrollo de patógenos, etc.Trabajo en equipoUn salto de laboratorio a la realidad que es clave. «El cambio climático está modificando radicalmente las condiciones de cultivo: aumentan las plagas y se intensifican los factores ambientales que debilitan a las plantas», subraya Aguilar. Y describe las dos situaciones de ‘estrés vegetal’: «el biótico (plagas y enfermedades) y el abiótico (estrés hídrico, salino y térmico)… ya no basta con eliminar el problema, es necesario fortalecer el cultivo». Hasta la fecha, Biorizon BioTech ha destinado más de 30 millones de euros en I+D, con el apoyo de la UE y distintas instituciones públicas, con soluciones aplicadas en cultivos de 70 países. Desde el CSIC subrayan la importancia de la innovación abierta: «la combinación de ciencia básica, aplicación y la agilidad de las startups nos permitirán llevar la biotecnología desde el laboratorio a los cultivos, impulsando soluciones reales para reducir el uso de químicos y avanzar hacia un modelo agrícola más sostenible», concluyen. Elaborados a partir de plantas, microorganismos o minerales, los biopesticidas son la evolución natural del sector agrícola. Innovación y sostenibilidad sobre el terreno en la transición de lo químico a lo biológico, con España en vanguardia, consolidada como ‘hub’ tecnológico en este ámbito. Todo un despliegue de maravillas como las propias del ARN de Interferencia y el ‘apagado de genes’: se diseñan moléculas que, al ser ingeridas por una plaga específica, ‘apagan’ un gen vital para su supervivencia, sin influir en ninguna otra especie del ecosistema. Es, literalmente, programar la naturaleza para defenderse.Un ejemplo de esta nueva era se demuestra, día a día, en los laboratorios de la Universidad de León. Carlos Barreiro, profesor titular del Departamento de Biología Molecular de la Facultad de Veterinaria (y miembro de SEBiot-Sociedad Española de Biotecnología), establece una situación de partida: «El sector agrícola se enfrenta constantemente a retos que necesita superar para poder garantizar su continuidad, con lo que ello representa respecto al nivel de conservación de variedades vegetales autóctonas, el mantenimiento de la población en el entorno rural y la preservación de una actividad de alto impacto en el PIB español y europeo». Desafíos legales (control del uso de fitosanitarios por la UE), productivos (aumento de la población mundial), económicos (competencia con otros productores con diferentes regulaciones) y climáticos (que favorecen la emergencia de nuevas plagas o la resistencia de las existentes).Barreiro coordina el proyecto BioBIVE, en línea con el concepto de transición de las prácticas agrícolas convencionales a las regenerativas propuesto por el Comité Económico y Social Europeo en 2025. «El control de plagas (destaca Barreiro) presenta varios puntos de actuación, como el combate contra los hongos (mohos) que afectan a cultivos (tres de los productos en los que España ocupa el ‘top 3’ de productores europeos: fresa, zanahoria y tomate, centran las actividades de BioBIVE). El desafío es lograr que el efecto no sea puntual, sino que se mantenga durante el tiempo necesario para proteger los cultivos». El proyecto propone tres formas de liberación controlada de los biopesticidas «el plástico biodegradable de mulch (mantillo), el biochar (biocarbón) y el novedoso mulch pulverizable, a partir de materiales biológicos (quitosano, pectina)». Como bonus, el proyecto abre una ventana de oportunidad para la industria del plástico en Europa «al ampliar su porfolio de productos hacia horizontes más ecosostenibles, lo que facilitará el mantenimiento de empresas».Trabajos de referenciaOtro ejemplo de referencia es la Universidad de Almería (Almería ya cuenta con más de 5.500 hectáreas de cultivo ecológico certificado), con proyectos como Greenfarm y Sabana (microalgas que llegan a ayudar a la planta a crecer y refuerzan sus defensas naturales contra patógenos), Adopt IPM (una alianza UE-China para luchar contra las plagas con una significativa reducción de químicos), el centro de investigación Ciambital, etc. Todo suma para que se pueda materializar la estrategia ‘De la Granja a la Mesa’ (‘Farm to Fork’), una iniciativa clave del Pacto Verde Europeo, lanzada en 2020, que aspira a reducir el uso de plaguicidas químicos en un 50% para finales de esta década. Un desempeño en el que los biopesticidas cuentan con tres vectores de desarrollo: la opción microbiana (microorganismos vivos como bacterias, hongos, virus o protozoos), la bioquímica (sustancias naturales que controlan plagas mediante mecanismos no tóxicos, como feromonas que confunden a los machos y evitan la reproducción) y los ‘Protectores incorporados’ (PIP), sustancias producidas por las plantas modificadas genéticamente con material de biopesticidas (con restricciones, eso sí, de la UE).La innovación abierta es clave para llevar la soluciones de laboratorio a los cultivosOtros de los laboratorios punteros en España son los del CSIC, cuyo Grupo de Bioplaguicidas desarrolla investigaciones en las que la ciencia aplicada convive con procesos industriales escalables. «El grupo no es solo un equipo de investigación, es una plataforma estratégica diseñada para acelerar el desarrollo de soluciones biotecnológicas antes de su uso en campo. Nuestro valor diferencial es integrar microbiología, genética, química verde, y escalado industrial en un mismo entorno», apuntan desde CSIC. Un equipo multidisciplinar trabaja en laboratorios especializados en microbiología, biología de insectos plaga y fitoparásitos, análisis metabolómico, formulación avanzada, compatibilidad agronómica y evaluación biológica, con invernaderos experimentales y campos de ensayo. Sus trabajos abarcan desde la prospección de plantas y el aislamiento de microorganismos, que produzcan metabolitos potencialmente activos para el control de plagas y enfermedades de los cultivos, «hasta el diseño de formulados de productos naturales que potencian la resiliencia de las plantas frente al estrés biótico». Una gama de posibilidades en las que exprimen su experiencia en el estudio del microbioma asociado a los suelos y plantas cultivadas y su función en los agroecosistemas, así como de la epidemiología de ciertos organismos fitopatógenos como hongos y nematodos.Desde la empresa Biorizon Biotech destacan cómo «los biopesticidas han pasado de ser alternativa emergente a convertirse en pieza clave en la transformación del modelo agrícola». Su aportación pasa por entenderlos no como productos aislados, sino como parte de un sistema tecnológico más amplio orientado a mejorar la resiliencia del cultivo, con desarrollos como la tecnología Trietech: una plataforma biotecnológica cuyo eje central es un sistema propio que integra distintas fuentes biológicas (microalgas, bacterias y extractos vegetales) para desarrollar soluciones agrícolas de alto valor añadido.Los laboratorios de CSIC son referentes en este ámbito; sobre estas líneas, un desarrollo de la Universidad de LeónProyecto BioBIVE: en la imagen, a la izquierda un hongo patógeno de plantas (fresa, zanahoria o tomate) y a la derecha un microorganismo capaz de retrasar el crecimiento de los patógenos. Las sustancias generadas o los propios microorganismos son los biopesticidas«La biotecnología y las microalgas (señala su director general, Sergio Aguilar) nos ofrecen innumerables soluciones futuras a través de la síntesis natural de los metabolitos con gran valor agronómico. Se integran en Trietech, que no se basa en un único ingrediente activo, sino en la combinación sinérgica de compuestos bioactivos naturales obtenidos mediante procesos biotecnológicos avanzados». Un círculo virtuoso de naturaleza y tecnología que consigue activar las defensas naturales del cultivo, mejorar el estado fisiológico de la planta, su refuerzo estructural, la interferencia en el desarrollo de patógenos, etc.Trabajo en equipoUn salto de laboratorio a la realidad que es clave. «El cambio climático está modificando radicalmente las condiciones de cultivo: aumentan las plagas y se intensifican los factores ambientales que debilitan a las plantas», subraya Aguilar. Y describe las dos situaciones de ‘estrés vegetal’: «el biótico (plagas y enfermedades) y el abiótico (estrés hídrico, salino y térmico)… ya no basta con eliminar el problema, es necesario fortalecer el cultivo». Hasta la fecha, Biorizon BioTech ha destinado más de 30 millones de euros en I+D, con el apoyo de la UE y distintas instituciones públicas, con soluciones aplicadas en cultivos de 70 países. Desde el CSIC subrayan la importancia de la innovación abierta: «la combinación de ciencia básica, aplicación y la agilidad de las startups nos permitirán llevar la biotecnología desde el laboratorio a los cultivos, impulsando soluciones reales para reducir el uso de químicos y avanzar hacia un modelo agrícola más sostenible», concluyen.
Elaborados a partir de plantas, microorganismos o minerales, los biopesticidas son la evolución natural del sector agrícola. Innovación y sostenibilidad sobre el terreno en la transición de lo químico a lo biológico, con España en vanguardia, consolidada como ‘hub’ tecnológico en este ámbito. Todo un … despliegue de maravillas como las propias del ARN de Interferencia y el ‘apagado de genes’: se diseñan moléculas que, al ser ingeridas por una plaga específica, ‘apagan’ un gen vital para su supervivencia, sin influir en ninguna otra especie del ecosistema. Es, literalmente, programar la naturaleza para defenderse.
Un ejemplo de esta nueva era se demuestra, día a día, en los laboratorios de la Universidad de León. Carlos Barreiro, profesor titular del Departamento de Biología Molecular de la Facultad de Veterinaria (y miembro de SEBiot-Sociedad Española de Biotecnología), establece una situación de partida: «El sector agrícola se enfrenta constantemente a retos que necesita superar para poder garantizar su continuidad, con lo que ello representa respecto al nivel de conservación de variedades vegetales autóctonas, el mantenimiento de la población en el entorno rural y la preservación de una actividad de alto impacto en el PIB español y europeo». Desafíos legales (control del uso de fitosanitarios por la UE), productivos (aumento de la población mundial), económicos (competencia con otros productores con diferentes regulaciones) y climáticos (que favorecen la emergencia de nuevas plagas o la resistencia de las existentes).
Barreiro coordina el proyecto BioBIVE, en línea con el concepto de transición de las prácticas agrícolas convencionales a las regenerativas propuesto por el Comité Económico y Social Europeo en 2025. «El control de plagas (destaca Barreiro) presenta varios puntos de actuación, como el combate contra los hongos (mohos) que afectan a cultivos (tres de los productos en los que España ocupa el ‘top 3’ de productores europeos: fresa, zanahoria y tomate, centran las actividades de BioBIVE). El desafío es lograr que el efecto no sea puntual, sino que se mantenga durante el tiempo necesario para proteger los cultivos». El proyecto propone tres formas de liberación controlada de los biopesticidas «el plástico biodegradable de mulch (mantillo), el biochar (biocarbón) y el novedoso mulch pulverizable, a partir de materiales biológicos (quitosano, pectina)». Como bonus, el proyecto abre una ventana de oportunidad para la industria del plástico en Europa «al ampliar su porfolio de productos hacia horizontes más ecosostenibles, lo que facilitará el mantenimiento de empresas».
Trabajos de referencia
Otro ejemplo de referencia es la Universidad de Almería (Almería ya cuenta con más de 5.500 hectáreas de cultivo ecológico certificado), con proyectos como Greenfarm y Sabana (microalgas que llegan a ayudar a la planta a crecer y refuerzan sus defensas naturales contra patógenos), Adopt IPM (una alianza UE-China para luchar contra las plagas con una significativa reducción de químicos), el centro de investigación Ciambital, etc. Todo suma para que se pueda materializar la estrategia ‘De la Granja a la Mesa’ (‘Farm to Fork’), una iniciativa clave del Pacto Verde Europeo, lanzada en 2020, que aspira a reducir el uso de plaguicidas químicos en un 50% para finales de esta década. Un desempeño en el que los biopesticidas cuentan con tres vectores de desarrollo: la opción microbiana (microorganismos vivos como bacterias, hongos, virus o protozoos), la bioquímica (sustancias naturales que controlan plagas mediante mecanismos no tóxicos, como feromonas que confunden a los machos y evitan la reproducción) y los ‘Protectores incorporados’ (PIP), sustancias producidas por las plantas modificadas genéticamente con material de biopesticidas (con restricciones, eso sí, de la UE).
La innovación abierta es clave para llevar la soluciones de laboratorio a los cultivos
Otros de los laboratorios punteros en España son los del CSIC, cuyo Grupo de Bioplaguicidas desarrolla investigaciones en las que la ciencia aplicada convive con procesos industriales escalables. «El grupo no es solo un equipo de investigación, es una plataforma estratégica diseñada para acelerar el desarrollo de soluciones biotecnológicas antes de su uso en campo. Nuestro valor diferencial es integrar microbiología, genética, química verde, y escalado industrial en un mismo entorno», apuntan desde CSIC. Un equipo multidisciplinar trabaja en laboratorios especializados en microbiología, biología de insectos plaga y fitoparásitos, análisis metabolómico, formulación avanzada, compatibilidad agronómica y evaluación biológica, con invernaderos experimentales y campos de ensayo. Sus trabajos abarcan desde la prospección de plantas y el aislamiento de microorganismos, que produzcan metabolitos potencialmente activos para el control de plagas y enfermedades de los cultivos, «hasta el diseño de formulados de productos naturales que potencian la resiliencia de las plantas frente al estrés biótico». Una gama de posibilidades en las que exprimen su experiencia en el estudio del microbioma asociado a los suelos y plantas cultivadas y su función en los agroecosistemas, así como de la epidemiología de ciertos organismos fitopatógenos como hongos y nematodos.
Desde la empresa Biorizon Biotech destacan cómo «los biopesticidas han pasado de ser alternativa emergente a convertirse en pieza clave en la transformación del modelo agrícola». Su aportación pasa por entenderlos no como productos aislados, sino como parte de un sistema tecnológico más amplio orientado a mejorar la resiliencia del cultivo, con desarrollos como la tecnología Trietech: una plataforma biotecnológica cuyo eje central es un sistema propio que integra distintas fuentes biológicas (microalgas, bacterias y extractos vegetales) para desarrollar soluciones agrícolas de alto valor añadido.

«La biotecnología y las microalgas (señala su director general, Sergio Aguilar) nos ofrecen innumerables soluciones futuras a través de la síntesis natural de los metabolitos con gran valor agronómico. Se integran en Trietech, que no se basa en un único ingrediente activo, sino en la combinación sinérgica de compuestos bioactivos naturales obtenidos mediante procesos biotecnológicos avanzados». Un círculo virtuoso de naturaleza y tecnología que consigue activar las defensas naturales del cultivo, mejorar el estado fisiológico de la planta, su refuerzo estructural, la interferencia en el desarrollo de patógenos, etc.
Trabajo en equipo
Un salto de laboratorio a la realidad que es clave. «El cambio climático está modificando radicalmente las condiciones de cultivo: aumentan las plagas y se intensifican los factores ambientales que debilitan a las plantas», subraya Aguilar. Y describe las dos situaciones de ‘estrés vegetal’: «el biótico (plagas y enfermedades) y el abiótico (estrés hídrico, salino y térmico)… ya no basta con eliminar el problema, es necesario fortalecer el cultivo». Hasta la fecha, Biorizon BioTech ha destinado más de 30 millones de euros en I+D, con el apoyo de la UE y distintas instituciones públicas, con soluciones aplicadas en cultivos de 70 países. Desde el CSIC subrayan la importancia de la innovación abierta: «la combinación de ciencia básica, aplicación y la agilidad de las startups nos permitirán llevar la biotecnología desde el laboratorio a los cultivos, impulsando soluciones reales para reducir el uso de químicos y avanzar hacia un modelo agrícola más sostenible», concluyen.
RSS de noticias de economia
